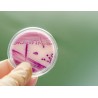
Vita Probio Lavavitae

Brak produktów
Vita Probio Lavavitae
- Napisz opinię
Vita Probio Lavavitae
VITA PROBIO zawiera 4 starannie dobrane szczepy bakterii.
Kompleksowe zarządzanie mikrobiomem.
https://www.lavavitae.com/shop?artSelect=11904
Przy składaniu zamówienia używając linku powyżej proszę podać
numer partnera:
ID : 6753100
Opis
VITA PROBIO – Probiotyk dla pełnej regeneracji jelit
Silna flora jelitowa to klucz do dobrego samopoczucia. Codziennie biliony mikroorganizmów w jelitach dbają o trawienie, odporność, poziom energii i nastrój. Kiedy jelita działają sprawnie, czujemy się lepiej i mamy więcej energii. Jednak stres, antybiotyki i niezdrowa dieta mogą zaburzyć tę równowagę, co prowadzi do problemów takich jak zmęczenie, wzdęcia czy osłabiona odporność.
NAJWAŻNIEJSZE CECHY PRODUKTU VITA PROBIO
-
-
-
Zdrowe jelita to dobre samopoczucie
Flora jelitowa wpływa na trawienie, odporność, energię i nastrój. Jej równowaga łatwo ulega zaburzeniom (np. przez stres, antybiotyki, dietę), co może prowadzić do wzdęć, zmęczenia czy osłabienia odporności. -
Skuteczna formuła 4 szczepów
Zawiera 4 synergicznie działające, naukowo przebadane szczepy: L. plantarum, L. rhamnosus GG, B. lactis, L. lactis, które wspierają mikrobiom i trawienie oraz wykazują działanie immunomodulujące, przeciwzapalne i antydepresyjne. -
Wysoka jakość i aktywność bakterii
Każda porcja zawiera minimum 2 miliardy żywych kultur bakterii, zdolnych do przetrwania w przewodzie pokarmowym. Ożywiają się już po 1 minucie od przygotowania. -
Wszechstronne działanie
Wspierają barierę jelitową, produkcję kwasów tłuszczowych SCFA, optymalne pH i różnorodność flory. Pomagają w profilaktyce i w trakcie antybiotykoterapii. -
Potwierdzone naukowo
Liczne badania potwierdzają skuteczność szczepów w poprawie snu, trawienia, odporności, nastroju i redukcji stanów zapalnych.Sposób użycia VITA PROBIO
-
Codzienne stosowanie:
1 saszetkę (2 g) rozpuścić w 1/8 l zimnej lub letniej wody. Odczekać 1 minutę, ponownie wymieszać i wypić.
Zalecane na czczo – przed śniadaniem lub kolacją. -
Dla kogo:
Odpowiedni dla kobiet w ciąży i dzieci od 1. roku życia.
-
W trakcie kuracji:
1 saszetka 2 razy dziennie. -
Po zakończeniu kuracji:
1 saszetka raz dziennie przez min. 14 dni. -
Uwaga:
Probiotyk należy przyjmować ok. 2–3 godziny po antybiotyku, zawsze na czczo, przed posiłkiem. - Zawartość: 30 saszetek po 2 g
-
-
-
ZAREJESTRUJ SIĘ JAKO AFFILIANT I ZBIERAJ PUNKTY W PROGRAMIE LOJALNOŚCIOWYM.
https://www.lavavitae.com/shop?artSelect=11904
Przy składaniu zamówienia używając linku powyżej proszę podać
numer partnera: